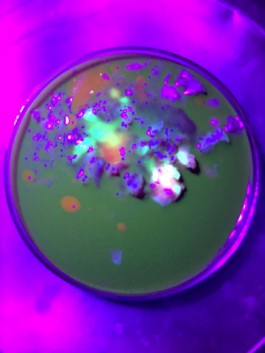

8. Poster Serie 3, Backside

3

9. Overview

8. Visual Experiements

13

8. Poster Serie 3

12

11

11. Book Design

6. Identity

13

9. Film Poster

1989, Switzerland, Basel

4. Exhibition Design

3. Manual/Lookbook

13. Lookbook

12. Logo Applied

7

3

3

2018, Pasta Dinner Upgraded

8. Sketches

2016–2018, Work Experience at Spin, London UK

8

13

1. Details, Different Paperstock

14. Catalogue Design

2. Poster Design

1. Cookbook

2019, Chinese letters

8. Poster Serie 1

4. Information Graphic

1

2022, Basel

12. Logo Design

3. Label

12

3

12. Lookbook

12. Logo Design

3. Logo Design

8. Details, Pantone Print

3. Logo Applied
9. Animated Wordmark

3. Packaging Design

12. Photography Selection

4. Signage

12. Stationary

5

7. Photography Book

8. Poster Serie 1–3, Packaging

2021, Venice Biennale, Finnish Pavilion

2017, Art Direction and Graphic Design

12. Mock Up

8

14

10. Lookbook

11. Artwork from Eva

11. Details

5. Architecture Book, Manual

5. Details, Indigo Print

8

2018–2022, in Amsterdam

14

1. Dim Sum, 2. BBC, 3. Christofori, 4. Collect, 5. Collado Collins, 6. Kleinhafen, 7. Leave before I wake up, 8. Living Matters, 9. MAMA, 10. Pellat Finet, 11. Give me your bones, 12. Songe-Creux 1, 13. Songe-Creux 2, 14. Shanghai Biennale 2019